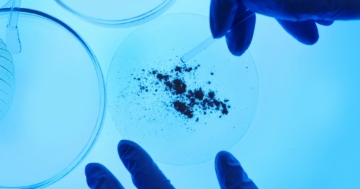

Farmaci
La conoscenza del corretto uso di farmaci e rimedi naturali riguarda un aspetto importante nella cura del bambino. Gli articoli che seguono vi offrono una panoramica sulle proprietà di questi prodotti, nonché un’attenta analisi sui rischi e i benefici per la salute.
Vaccinazioni: effetti collaterali

Le vaccinazioni possono avere piccoli effetti collaterali: è del tutto normale e non bisogna preoccuparsi. Quali sono e come si trattano?
Vaccinazioni: precauzioni e controindicazioni

In alcuni, rari, casi il vaccino può presentare delle controindicazioni e in altri, meno gravi, bisogna prendere delle precauzioni. Più diffuse e pericolose sono invce le “false controindicazioni”, che non hanno alcun fondamento scientifico
Come funziona e a cosa serve un vaccino

Com'è fatto un vaccino? E perché è importante vaccinarsi? Ce lo spiega il pediatra
La camomilla non è un sonnifero

È utilizzata fin dai tempi degli antichi greci, ma gli studi non confermano le sue proprietà sedative e favorenti il sonno, bensì la sua azione antinfiammatoria e antispastica a livello dello stomaco e dell’intestino
Cranberry per trattare le infezioni delle vie urinarie

Il cranberry veniva tradizionalmente usato per il trattamento dei problemi renali, della vescica e di altre malattie. Le sue proprietà come disinfettante delle vie urinarie sono state studiate con i metodi delle medicina moderna
Resistenza antibiotica: cosa rischiamo?
Resistenza antibiotica: quali sono i rischi? Gli studiosi lanciano l'allarme sui problemi di batteri resistenti agli antibiotici
La melissa, un calmante naturale

I medici arabi dicevano che la melissa aveva la capacità di allontanare l'ansia e la tristezza che impediscono il sonno. Seppure non sia ancora del tutto chiaro come funzioni questa pianta, gli studi hanno confermato i suoi effetti benefici
Le virtù terapeutiche del sambuco

Il sambuco, usato sin dall'antichità per le sue virtù terapeutiche, è un ottimo alleato naturale contro l'influenza. Scopriamo le sue caratteristiche antinfiammatorie e antiossidanti e in che modo può aiutare a combattere i sintomi influenzali.
Vaccino contro lo pneumococco: efficacia e sicurezza

Il vaccino è cambiato nel corso del tempo e quello che si utilizza oggi agisce contro tutti e tredici gli attuali ceppi di pneumococco, batterio che abita le vie aeree di adulti e bambini
Utilizzo dei fitoterapici in pediatria

L'utilizzo di piante medicinali è in crescita, ma non sempre sotto la guida del medico. Vediamo cosa c'è da sapere sulla fitoterapia e come usarla per curare i bambini
Integratori e vitamina D

Le vitamine sono un insieme di sostanze chimiche necessarie per il corretto funzionamento del nostro organismo, ma se assunte in eccesso possono risultare dannose
Tutto sull’olio di Melaleuca alternifolia (tea tree oil)

L’olio di Melaleuca alternifolia (tea tree oil) ha effetti positivi su problemi della pelle causati da batteri o funghi e su infiammazioni dovute a punture d’insetto, sostanze irritanti e altri fattori
Echinacea: un valido aiuto al sistema immunitario

Nel periodo invernale i bambini si ammalano frequentemente, perché il loro sistema immunitario si sta ancora sviluppando. L’echinacea, pianta originaria del Nord America e del Messico, è un valido rimedio naturale
La propoli: un rimedio efficace in molti casi

È il prodotto di origine naturale più usato senza consiglio del medico. Le sue proprietà curative erano già note ai tempi degli Egizi, e i Greci e i Romani la usavano per disinfettare le ferite.
Terapia per la tosse: quale scegliere?

L'unica sostanza che abbia avuto il beneplacito della letteratura ufficiale come efficace sul fastidio e l'intensità della tosse notturna è il miele, che comunque non è indicato al di sotto dell’anno di età. L’uso di farmaci per la tosse, invece, non ha riscontrato alcuna evidenza di efficacia superiore a quella del placebo
La tosse si cura con il cortisone?

Cortisone e antistaminici vengono talvolta usati come rimedi contro la tosse. A torto o a ragione? Il pediatra risponde
Argotone e Argento proteinato per liberare il naso

Il loro uso continuo e spesso esagerato può danneggiare la mucosa del naso, tanto da rendere il rimedio peggiore del male
Vaccini e autismo: cosa c’è di vero?

Non c'è nessuna evidenza scientifica che dimostri una correlazione di alcun tipo tra vaccini e sviluppo di disturbi dello spettro autistico: lo spiegano i nostri pediatri
Aerosol: utilizzo nei bambini

L'aerosol è uno strumento utilizzato frequentemente dai genitori. Ma attenzione: bisogna usarlo in maniera corretta e conoscere i disturbi per cui è uno strumento terapeutico efficace
Prima della farmacia: la sperimentazione

Come avviene la sperimentazione di un farmaco? Quali sono le fasi prima della vendita in farmacia? Scopriamo insieme come funziona la sperimentazione di un farmaco e quali test vengono effettuati prima dell'arrivo in commercio.
Uso dei probiotici (“fermenti lattici”) nei bambini

I probiotici sono batteri che si trovano nel nostro intestino e contribuiscono al suo buon funzionamento, ma vengono venduti anche in farmacia e nei supermercati. Ha senso farli assumere ai bambini in caso di determinati squilibri?